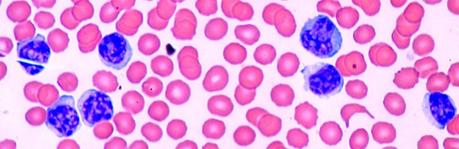
Linfocitos altos

Los linfocitos son una parte fundamental de nuestro sistema inmunológico. Son los que identifican los elementos extraños en el cuerpo y lo defienden de las infecciones. Por ello, es normal que en ocasiones el número de linfocitos aumente de forma temporal. Si dicho aumento se prolonga en el tiempo, estamos ante una linfocitosis.
Recuento de linfocitos
Un hemograma completo nos indicará el porcentaje de linfocitos por el número total de leucocitos en sangre.
¿Qué entendemos por linfocitos altos? En un adulto, el porcentaje normal es de entre 1500 y 4000 células por microlito de sangre. Un recuento de 3000 linfocitos puede ser indicativo de una linfocitosis. En los niños, puede variar en función de la edad, pero un recuento anormal puede alcanzar entre 7000 y 9000 linfocitos por microlito de sangre.
Síntomas de los linfocitos altos
Un aumento de los glóbulos blancos o linfocitos altos puede no manifestar ningún síntoma. Los cambios experimentados por el organismo serían aquellos provocados por la enfermedad que causa la linfocitosis.
Algunos síntomas pueden ser:
- Fiebre, es decir, un aumento de la temperatura corporal.
- Sangrado anormal o moretones.
- Cansancio o debilidad física.
- Mareos o desvanecimientos.
- Sudoración inexplicable.
- Hormigueo o entumecimiento en brazos, piernas o abdomen.
- Dificultad para respirar.
- Dificultad para pensar con claridad o ver bien.
- Pérdida de peso repentina e inexplicable.
Una vez estudiado el hemograma completo del paciente, será el médico el que determine si se trata de una linfocitosis temporal o permanente. Después, deberá identificar la causa concreta que causa ese aumento, si es consecuencia de una infección o de cualquier otra enfermedad.
Causas de los linfocitos altos
Si el médico constata un aumento anormal del número de linfocitos, esto puede poner de manifiesto la existencia de:
- Una infección bacteriana, viral o de otro tipo.
- Un trastorno autoinmune que causa inflamación crónica.
- Cáncer de la sangre o del sistema linfático.
Dentro de este esquema general, existen una serie de enfermedades concretas que causan linfocitosis: tos ferina, vasculitis, mieloma múltiple, mononucleosis, VIH / SIDA, infección por citomegalovirus, leucemia linfocítica aguda y leucemia linfocítica crónica.

Vasculitis
Se produce cuando los vasos sanguíneos se inflaman y provocan cambios en las paredes. Puede ser temporal o puede resultar crónico. Los casos más graves son aquellos donde se bloquea el flujo sanguíneo que va a los órganos y se causan daños en en los tejidos.
Tos ferina
Es una tos muy fuerte acompañada por un ruido respiratorio convulsivo. Por norma general, las enfermedades respiratorias pueden causar un aumento del nivel de linfocitos.
Mononucleosis
Es una infección viral que se propaga a través de la saliva.
Alguno de sus síntomas son la fiebre, el dolor de garganta e inflamación de los ganglios linfáticos, especialmente los del cuello.
VIH/SIDA
El SIDA es una enfermedad causada por el virus de inmunodeficiencia humana que daña el sistema inmunitario.
Se trasmite por el contacto sexual, pero en la actualidad no es necesariamente mortal, pudiendo convivir los afectados con la enfermedad y llevar una vida normal.
Mieloma múltiple
Es un tipo de cáncer que afecta a las células plasmáticas, que son un tipo de glóbulos blancos presentes en la médula ósea y que producen anticuerpos para combatir las infecciones.
Infección por citomegalovirus
El citomegalovirus es un virus que se propaga por los fluidos corporales. La mayoría de personas que lo sufren no presentan síntomas, si bien es una enfermedad que, una vez adquirida, permanece para siempre en nuestro organismo de forma latente.
Leucemia linfocítica crónica
Es un cáncer de la médula ósea y sangre. La calificación de ‘crónica’ significa que progresa más lentamente que cualquier otra leucemia.
Algunos de los síntomas típicos de esta enfermedad son la pérdida de peso, el crecimiento de los ganglios linfáticos, fatiga crónica y el padecimiento de infecciones de forma frecuente.
Leucemia linfocítica aguda
Es un cáncer de la médula ósea y la sangre. Su calificación de ‘aguda’ se debe a su rápido progreso en el tiempo.
Alguno de los síntomas que presenta además de un incremento de linfocitos es la hinchazón de nódulos linfáticos que provoca bultos, fiebre, hemorragias nasales, infecciones, dolor de huesos y un sangrado anormal de las encías.
Este tipo de leucemia es la que se da con mayor frecuencia en los niños.
Riesgos y tratamiento
El riesgo que conlleva un recuento alto de linfocitos es que es indicador de que algo en nuestro organismo no va bien. Generalmente será consecuencia de una reacción del sistema inmunológico a un determinado virus o infección, que con el tratamiento adecuado y reposo, se solventará. Sin embargo, también puede ser el indicador de otro tipo de enfermedades graves como las descritas, que provocan una respuesta de nuestro sistema inmune para combatirlas.
Como se ha visto, la linfocitosis no es en sí una enfermedad, sino el indicador de que algo está atacando a nuestro sistema inmunológico. Por ello, sirve de alarma para detectar problemas subyacentes. Será el especialista el que identifique la enfermedad o patología que causa ese recuento anormal de linfocitos y prescriba el tratamiento adecuado para la causa que lo provoca.
